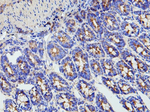
MMP16 Antibody in Immunohistochemistry (Paraffin) (IHC (P))

Search
Rockland
MMP16 Polyclonal Antibody
{{$productOrderCtrl.translations['antibody.pdp.commerceCard.promotion.promotions']}}
{{$productOrderCtrl.translations['antibody.pdp.commerceCard.promotion.viewpromo']}}
{{$productOrderCtrl.translations['antibody.pdp.commerceCard.promotion.promocode']}}: {{promo.promoCode}} {{promo.promoTitle}} {{promo.promoDescription}}. {{$productOrderCtrl.translations['antibody.pdp.commerceCard.promotion.learnmore']}}
图: 1 / 4
MMP16 Antibody (600-401-P76) in IHC (P)

产品信息
600-401-P76
种属反应
宿主/亚型
分类
类型
抗原
偶联物
形式
浓度
规格
纯化类型
保存液
内含物
保存条件
运输条件
靶标信息
Matrix metallopeptidase 16 during embryonic development, reproduction, and tissue remodeling. MMP-16 is also involved in the ECM degradation processes associated with arthritis and metastasis. In humans, MMP-16 is a part of a cluster of MMP genes at the 11q22.3 locus.
⚠WARNING: This product can expose you to chemicals including mercury, which is known to the State of California to cause birth defects or other reproductive harm. For more information go to www.P65Warnings.ca.gov.
仅用于科研。不用于诊断过程。未经明确授权不得转售。
篇参考文献 (0)
生物信息学
蛋白别名: DKFZp761D112; matrix metallo protease; matrix metallopeptidase 16 (membrane-inserted); matrix metalloproteinase 16; Matrix metalloproteinase-16; Membrane type 3-MMP; Membrane-type matrix metalloproteinase 3; Membrane-type-3 matrix metalloproteinase; MMP; MMP-1; MMP-16; MMP-X2; MMPs; MT-MMP 3; MT3-MMP; MT3MMP; MTMMP3; Putative transmembrane protein C8orf57; unnamed protein product
基因别名: C8orf57; MMP-X2; MMP16; MMPX2; MT-MMP2; MT-MMP3; MT3-MMP; Mt3mmp
UniProt ID: (Human) P51512, (Rat) O35548, (Mouse) Q9WTR0
Entrez Gene ID: (Human) 4325, (Rat) 65205, (Mouse) 17389




